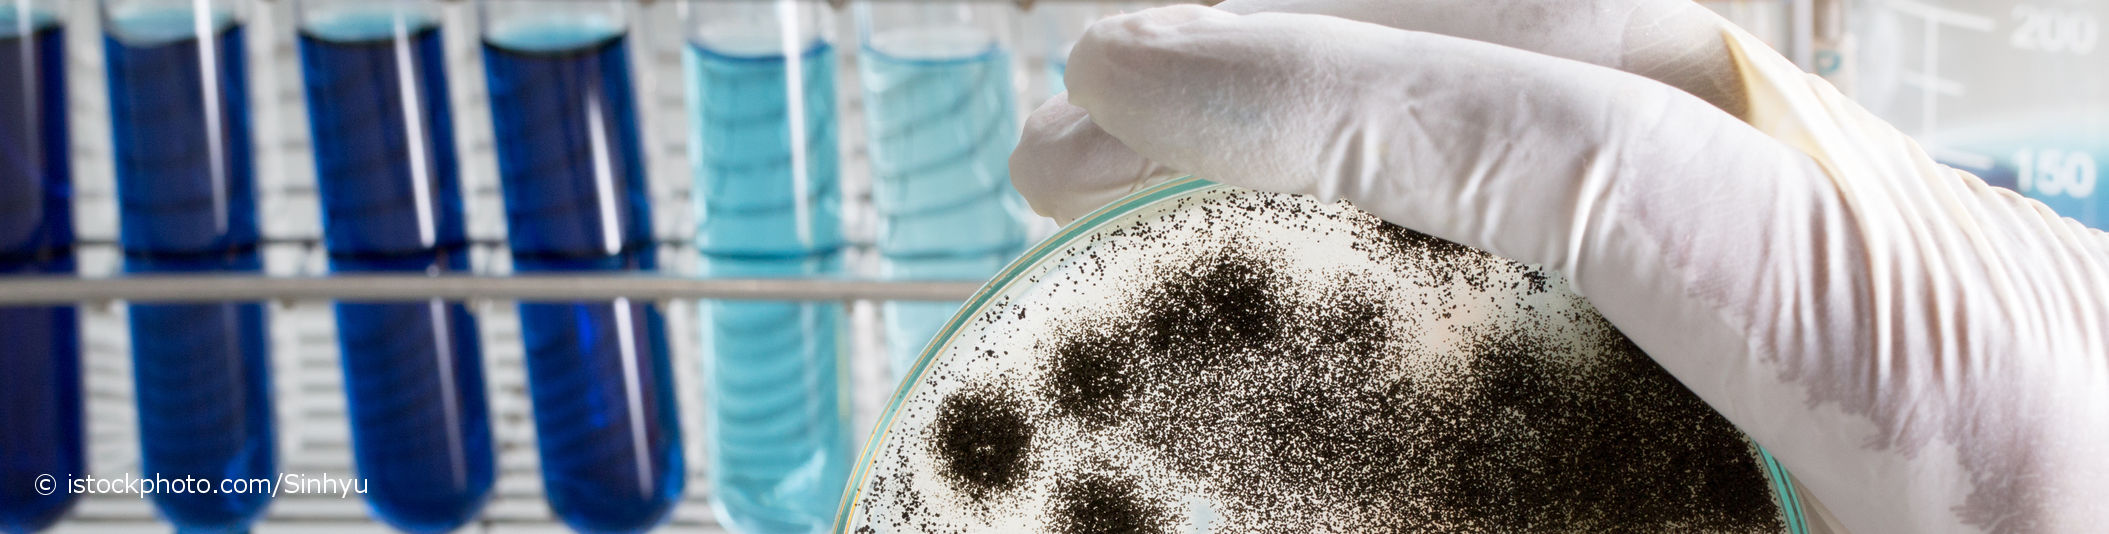

FA Hygiene und Umweltmedizin
Was ist ein Facharzt für Hygiene und Umweltmedizin?
Der Facharzt für Hygiene und Umweltmedizin wird auch als Hygieniker oder Umweltmediziner bezeichnet.
Im Arbeitsbereich der Umweltmedizin beschäftigt sich der Facharzt für Hygiene und Umweltmedizin mit den Auswirkungen der Umwelt auf die Gesundheit des menschlichen Körpers. Dabei hat der Facharzt für Hygiene und Umweltmedizin sowohl den einzelnen Menschen als auch die Gesundheit der Bevölkerung im Blick.
- Der FA für Hygiene und Umweltmedizin ist in der Erkennung, Überprüfung und Bewertung von potentiell schädlichen Umwelt-Einwirkungen oder giftigen Stoffen auf den Einzelnen geübt. Substanzen oder Ereignisse, die dem Organismus Schaden zufügen, werden als Noxen bezeichnet. Beispiele für schädliche Umwelt-Einwirkungen sind bestimmte Baumaterialien oder auch Lärmbelästigungen.
- Der Umweltmediziner führt komplizierte Messungen und Untersuchungen am Betroffenen durch. Eine davon ist das sogenannte Humane Biomonitoring, bei dem bestimmte Fremdstoffe zum Beispiel im Blut der betroffenen Person gemessen werden. So lässt sich zum Beispiel eine Aussage darüber treffen, wie sehr dein Körper durch einen bestimmten Schadstoff belastet ist. Auch Untersuchungen der Umwelt und Umgebung werden zum Beispiel in Form von Ortsbegehungen und bestimmten chemischen oder mikrobiologischen Untersuchungsmethoden vorgenommen.
- Ebenso diagnostiziert und behandelt ein Umweltmediziner Umwelt-bedingte, also durch Umweltfaktoren verursachte oder Umwelt-bezogene, also durch die Umwelt mit beeinflusste Beschwerden und Erkrankungen.
- Ein Schwerpunkt der Tätigkeit eines Umweltmediziners besteht in der Prävention, also Verhinderung von Gesundheitsschäden durch die Umwelt.
- Auch mit den Themen Verbraucherschutz und der Gesundheit der Gesamtheit beschäftigt sich der Umweltmediziner. Prüfungen bestimmter Stoffe zum Beispiel in Hinblick auf ihre Unbedenklichkeit oder auf die Frage, ob der Stoff Krebs erregen kann, spielen zum Beispiel in der Debatte um den Unkraut-Vernichter Glyphosat eine Rolle.
Im Bereich der Hygiene befasst sich der Facharzt für Hygiene und Umweltmedizin beispielsweise mit der Sauberkeit unseres Wassers, der Bäder, des Bodens, der Abwässer oder unserer Lebensmittel. Aber auch die Krankenhaushygiene und die Erstellung und Auswertung zum Beispiel von krankenhaushygienischen Statistiken gehört zum Aufgabenbereich des Facharztes für Hygiene und Umweltmedizin. Er berät und unterstützt Krankenhäuser, Institutionen oder Ärzte in Themen der Hygiene, der Umweltmedizin oder des Gesundheitsschutzes.
Ausbildung zum Facharzt für Hygiene und Umweltmedizin
Der Werdegang zum Facharzt für Hygiene und Umweltmedizin beginnt mit einem abgeschlossenen Medizinstudium und der Erlaubnis zur Ausübung des Arztberufes (Approbation). Die Weiterbildung zum Facharzt für Hygiene und Umweltmedizin dauert insgesamt 60 Monate.
Während der Weiterbildung kann der Assistenzarzt bis zu 12 Monte in einem anderen Fachgebiet der Patientenversorgung und bis zu 12 Monate in Fachbereichen wie beispielsweise der Arbeitsmedizin, Mikrobiologie oder Pharmakologie ableisten.
Wo arbeitet ein Facharzt für Hygiene und Umweltmedizin?
Ein Facharzt für Hygiene und Umweltmedizin kann stationär in Krankenhäusern oder Hochschulkliniken tätig sein. Auch Gesundheitsämter oder medizinische Labore bieten Beschäftigungsmöglichkeiten. Ebenso ist eine Niederlassung in einer Facharzt-Praxis, Ambulanz oder Beratungsstelle möglich. Ein FA Hygiene und Umweltmedizin findet auch Anstellungen in der medizinische Forschung und Lehre.
Wann gehst du zum FA Hygiene und Umweltmedizin?
Ist der Holzlack in deiner neuen Fachwerk-Wohnung Schuld an deinen Atemwegs-Problemen? Ist die Schimmelbelastung in deiner Wohnung schädlich für deine Gesundheit? Ist dein Ausschlag auf deine neuen Kosmetika zurückzuführen? Belasten die Abgase der Müllverwertungs-Anlage deine Raumluft im Wohnumfeld? Ist die Radon-Belastung deines Hauses zu hoch, sodass du gefährdet bist, an Lungenkrebs zu erkranken? Woran liegt es, dass deine Schleimhäute immer gereizt sind, wenn du mehrere Stunden am Arbeitsplatz verbracht hast? Werden gewisse Grenzwerte von schädlichen Stoffen im Trinkwasser eingehalten? Bist du durch giftige Stoffe in deiner Umwelt gefährdet?
Wenn du dir eine dieser Fragen bereits einmal gestellt hast oder einen Zusammenhang zwischen deinen Beschwerden und deiner Umgebung siehst, kann dich dein Hausarzt zum Facharzt für Hygiene und Umweltmedizin überweisen. Hier kann dir eine umweltmedizinische Beratung Aufschluss über deine Fragen geben.
In Fragen der Infektions-Vorbeugung (Prävention) und Hygiene, zum Beispiel in öffentlichen Einrichtungen, Krankenhäusern oder bei der Planung von Hygienekonzepten und dem Bau von Krankeneinrichtungen, kann der FA für Hygiene und Umweltmedizin ebenfalls der Ansprechpartner sein.
Untersuchungen beim Facharzt für Hygiene und Umweltmedizin
Um herauszufinden, ob dein Körper durch einen Schadstoff belastet ist, kann der FA Hygiene und Umweltmedizin verschiedene Untersuchungen durchführen:
- Ausführliche Anamnese: Der Umweltmediziner befragt dich ausgiebig zu deinen Beschwerden und deinen Vorstellungen und Befürchtungen, was Grund dieser Beschwerden sein kann. Dabei legt der Facharzt für Hygiene und Umweltmedizin Wert darauf, sich ein umfassendes Bild deiner Problematik zu machen und befragt dich möglicherweise auch zu deinen Ernährungsgewohnheiten, deinem Arbeitsplatz und weiteren lebensstilbezogenen Gesundheitsfaktoren.
- Klinische Untersuchungsmethoden: Beim Facharzt für Hygiene und Umweltmedizin kommen zum Teil die gleichen Untersuchungsverfahren zum Einsatz, wie in anderen Fachgebieten. Beziehen sich deine Beschwerden auf die Lunge oder geht es in der Abklärung um einen möglicherweise schädigenden Stoff für die Lunge, kann der Umweltmediziner einen Lungenfunktionstest durchführen. Dabei misst er verschiedene Funktionsparameter deiner Lunge oder beauftragt eine Röntgen-Aufnahme deiner Lunge. Möchte der Umweltmediziner sich zur Klärung deiner Symptome einen Überblick über deine Organe verschaffen, kann er einen Ultraschall (Sonographie) durchführen. Dadurch kann er die Struktur und das Aussehen deiner Organe beurteilen.
- Allergologische Diagnostik: In der Abklärung einer Allergie, zum Beispiel einer durch Schimmelpilzbefall der Wohnung ausgelösten allergischen Lungenerkrankung, kann der FA Hygiene und Umweltmedizin allergologische Testungen durchführen. Dazu gehören bestimmte Blut-Untersuchungen und Haut-Tests. Einer dieser Haut-Tests ist der sogenannte Prick-Test. Dabei werden dir verschiedene Lösungen mit möglichen Allergenen (Allergie auslösenden Stoffen) auf die Haut aufgetragen. Dann wird mit einem kleinen Pieks an der Teststelle eine minimale Verletzung der Haut hervorgerufen, damit das Allergen auch sicher mit deinem Immunsystem in Kontakt kommt. Bildet sich danach eine Rötung oder eine Quaddel ist der Test positiv. Ein weiterer Test ist der Epikutantest. Dabei werden verschiedene, mögliche Allergene mithilfe von Pflastern auf die Haut am Rücken geklebt. Die Pflaster bleiben bis zu 96 Stunden kleben. Danach werden die Pflaster gelöst und die Hautreaktionen beurteilt. Der Epikutantest dient dazu einen Allergie-Typen nachzuweisen, bei dem die allergische Reaktion der Haut erst verzögert beziehungsweise nicht sofort auftritt. Dieser Test wird zum Beispiel bei der Fragestellung nach einer Allergie gegen bestimmte Arbeitsstoffe oder Kosmetika durchgeführt.
- Humanes Biomonitoring: Mithilfe des Humanen Biomonitorings kann der Facharzt für Hygiene und Umweltmedizin messen, wie sehr dein Körper durch einen bestimmten Schadstoff belastet ist. Dazu wird dir zum Beispiel Blut entnommen und auf die Menge des vorhandenen Schadstoffs untersucht. Für viele Schadstoffe existieren Grenzwerte, sogenannte HBM-Werte (Humanes Biomonitoring-Werte). Werden diese Werte überschritten, sind genaue Anweisungen hinterlegt, was in dem Fall zu tun ist. Diese Untersuchungen können je nach Schadstoff auch mit Gewebeproben, Urin, Stuhl, Speichel, Haaren oder anderen Teilen des Körpers durchgeführt werden.
- Effektmonitoring: Ähnlich dem Humanen Biomonitoring untersucht der Umweltmediziner beim Effektmonitoring deinen Körper. Damit möchte er herausfinden, ob dein Körper gesundheitlich durch einen Schadstoff belastet ist. Der Umweltmediziner untersucht Veränderungen deines Körpers, die durch die Schadstoffeinwirkung hervorgerufen werden. Veränderungen können zum Beispiel an deiner Erbsubstanz (DNA, Desoxyribonukleinsäure) auftreten oder an Eiweißen, wie zum Beispiel dem roten Blutfarbstoff Hämoglobin. Normalwerte für Hämoglobin. Der Facharzt für Hygiene und Umweltmedizin kann Zellen und Botenstoffe deines Immunsystems untersuchen und schauen, ob dein Immunsystem infolge der Umweltbelastung sehr aktiv ist und eine Entzündung vorliegt. Als Untersuchungsmaterial dient dem FA Hygiene und Umweltmedizin zum Beispiel eine Blutprobe.
- Ortsbegehung, Umweltmonitoring: Bei einer Ortsbegehung und beim Umweltmonitoring untersucht der Umweltmediziner äußere, möglicherweise schädliche Belastungen in deinem häuslichen oder privaten Umfeld. Dabei achtet der Facharzt für Hygiene und Umweltmedizin darauf, ob beispielsweise bestimmte Holzschutzmittel, Stäube, ein besonderes Klima oder Schimmelpilze eine gesundheitliche Belastung für dich darstellen können.
- Hygiene und Infektions-Vorbeugung: Im Bereich der Hygiene führt der Hygieniker unterschiedliche Messungen und Untersuchungen durch. Hier kommen beispielsweise mikrobiologische Verfahren zum Einsatz. Möchte der FA Hygiene und Umweltmedizin zum Beispiel die Keim-Belastung eines Bereiches im Krankenhaus überprüfen, kann er Abstriche oder ähnliche Untersuchungsmaterialien aus diesem Bereich gewinnen. Die Erreger-Kulturen werden anschließend im Labor auf Nährmedien angezüchtet und vermehrt. Danach kann der Facharzt für Hygiene und Umweltmedizin das Ergebnis unter dem Mikroskop betrachten und bewerten. Ist der gefundene Keim gefährlich für das Krankenhaus? Sind zu viele Keime vorhanden? Aus seinen Untersuchungen kann der Hygieniker Rückschlüsse auf Hygienepläne ziehen und neue Strategien zur Infektionsverhütung und Bekämpfung von Infektionen entwickeln.
Medizin-Dolmetscher
Diagnosekürzel
Um Krankheiten einheitlich zu definieren, benutzen Ärzte, Zahnärzte und Psychologen auf Arbeitsunfähigkeitsbescheinigungen den Diagnoseschlüssel ICD-10. Hier findest du die Übersetzung der einzelnen ICD-10 Codes.
ICD-10 Diagnosen finden
Laborwerte
Wissenswertes über Blutwerte, Urinwerte und Werte aus Stuhlproben. Hier erfährst du, wofür die Abkürzungen stehen, welche Werte normal sind, was Abweichungen bedeuten können und was du zur Verbesserung der Werte tun kannst.
Laborwerte verstehen
Impfungen
Hier findest du Impfungen, empfohlene Reiseimpfungen sowie Wissenswertes zu Grundimmunisierung, Auffrischungsterminen und Impfstoffen.
Impf-Infos und Impfschutz